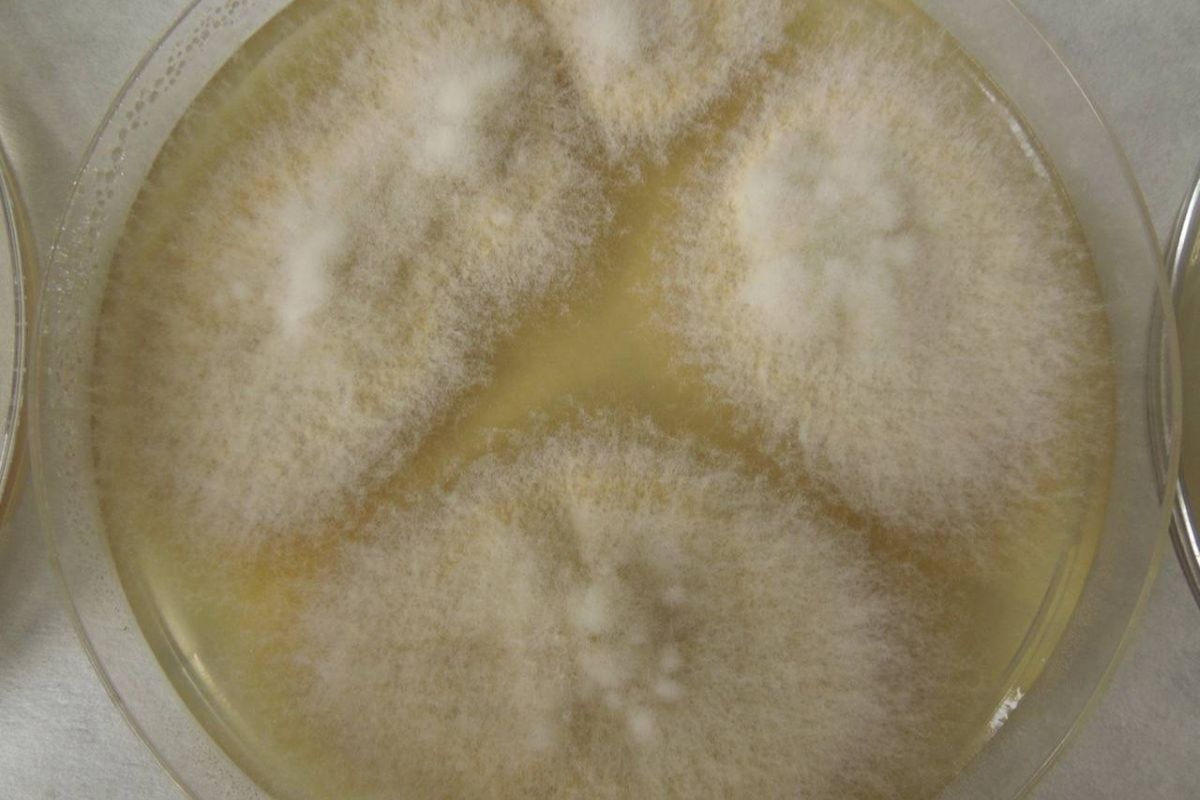
Kineski znanstvenici optimiziraju jestive gljive pomoću CRISPR-a kako bi dobili 88% više proteina uz 44% manje potrošnje resursa detail 2

Nakon uklanjanja jednog gena, gljiva raste uz manju količinu šećera. Nakon uklanjanja drugog, smanjuje se količina hitina, zahvaljujući čemu stanične stijenke postaju tanje i lakše probavljive. Soj FCPD pokazao je bolji okus, konzistenciju i veći udio masti, približavajući se teksturi piletine.
Ovo otkriće donosi niz ključnih točaka za budućnost prehrane:
- Optimizirani protein gljiva: Veća učinkovitost uz manje resursa.
- CRISPR kao nevidljivi akcelerator: Promjene u hrani postaju brže i preciznije.
- Mikroprotein s „mesnatijom” teksturom: Poboljšano iskustvo konzumacije.
- Manja potrošnja zemlje i vode: Značajna prednost u usporedbi s proizvodnjom mesa.
- Realna opcija za smanjenje pritiska na stočarstvo: Održiva alternativa.
- Društvena rasprava: Genetski modificirani organizmi, prihvaćanje i regulative.
Mogu li genetski modificirane gljive zamijeniti životinjske proteine? Mikroskopske gljive već se desetljećima pojavljuju na radaru održive prehrane, ali uvijek u malom opsegu i s opravdanim sumnjama: imaju li uvjerljivu teksturu? Koja je njihova cijena? Jesu li društveno prihvaćene? Uređivanje gena pomoću CRISPR-a počinje utirati put i sugerira nešto što bi prije pet godina zvučalo pretjerano: protein gljiva koji je hranjiviji, jeftiniji za proizvodnju i mnogo sličniji mesu.
Tehnološki skok u dva gena
Timu sa Sveučilišta Jiangnan uspjelo je transformirati Fusarium venenatum, gljivu koja čini osnovu proizvoda kao što je Quorn, uređivanjem samo dva gena. Nije dodana vanjska DNK: jednostavno su isključene određene funkcije. Rezultat je bio iznenađujući.
Nova linija, nazvana FCPD, generirala je 88% više proteina, trošeći pritom 44% manje hranjivih tvari. Odnos uloga i prinosa — ključan u svakom modernom prehrambenom sustavu — značajno se poboljšao. Za sektor koji se još uvijek bori za cjenovnu konkurentnost u odnosu na meso, ovakav napredak nije beznačajan: šećer i dušik koji se koriste kao hrana za gljive čine značajan dio konačnog troška proizvoda.

Prema istraživačkom timu, mutacije su utjecale na dva ključna procesa:
- Učinkovitiji rast: Smanjuje potrebu za šećerom.
- Manje hitina u staničnim stijenkama: Uzrokuje smanjenje debljine stanica i olakšava probavu ljudskom organizmu.
Dobivena gljiva zadržava svoju prirodnu vlaknastu strukturu, ali se sada lakše pretvara u hranu mekše i hranjivije konzistencije.
Tekstura mnogo sličnija piletini
Tekstura je velika Ahilova peta mnogih alternativnih biljnih proizvoda. U drugoj studiji, tim je procijenio okus dviju varijanti F. venenatum modificiranih pomoću CRISPR-a. Soj FCPD pokazao je teksturu vrlo sličnu pilećim prsima: veću elastičnost, veću koheziju i ujednačeniji osjećaj u ustima.
Zanimljivo je da ovaj napredak proizlazi iz malog povećanja udjela masti, koji omekšava konzistenciju i eliminira „spužvasti” okus tipičan za neke mikroproteine.
Analiza je uključivala metodu koja je jednako malo glamurozna koliko i učinkovita: 27-godišnji volonter žvakao je različite uzorke, a znanstvenici su zatim analizirali tu smjesu pomoću uređaja za ispitivanje teksture. Znanost je ponekad prozaična, ali korisna.
Ozbiljan kandidat za smanjenje potrošnje životinjskih proteina
Međunarodni pritisak na smanjenje klimatskog otiska mesa — posebno govedine — stvara povoljne uvjete za alternativne proteine koji doista funkcioniraju. Mahunarke ostaju najodrživija i najjeftinija opcija, ali ne želi svatko jesti mahunarke svaki dan. Mikroprotein stoga predstavlja „kulturni most”: u kuhinji se ponaša i ima okus sličniji mesu, olakšavajući prijelaz na prehranu s niskim udjelom životinjskih proteina.
Ova gljiva nije novost. Već je 60-ih godina razvijena za potrebe tržišta, a 80-ih je odobrena njezina prodaja u Velikoj Britaniji. Tvrtke poput Quorna dokazale su da mikroprotein može biti osnova profitabilne industrije. Ipak, sektor se godinama nalazi u stagnaciji. Poboljšanja koja donosi CRISPR mogu ponovno potaknuti interes i smanjiti troškove proizvodnje.
Kakav je utjecaj na okoliš?
U svojoj usporednoj analizi, znanstvenici su primijetili da soj FCPD ne nadmašuje biljne proteine u pogledu održivosti — mahunarke i grašak i dalje su na čelu — ali značajno smanjuje utjecaj na okoliš u usporedbi s tradicionalnim uzgojem gljiva, peradarskim mesom i uzgojenim mesom.
Prema istraživanju, rezultati su impresivni:
- 70% manja potrošnja zemlje nego pri proizvodnji piletine u Kini.
- 78% manji rizik od onečišćenja slatke vode.
Ovo je bitno: piletina je već jedna od vrsta mesa s najmanjim klimatskim otiskom. Ako je modificirana gljiva može nadmašiti, čak i ako se ne natječe s najučinkovitijim biljnim usjevima, otvara se zanimljiv međuprostor: proizvodi „mesnatiji” od mahunarki, ali sa znatno manjim utjecajem na okoliš od uzgoja životinja.
U trenutku kada EU preispituje svoje strategije o alternativnim izvorima proteina, a mnoge zemlje uvode poticaje za smanjenje ovisnosti o stočarstvu, ova kategorija hrane mogla bi se dobro pozicionirati, pod uvjetom da je potrošači prihvate.
Obećanje — i kočnica — CRISPR tehnologije
Stručnjaci u području mikroproteina ističu da je postizanje tako velikih poboljšanja korištenjem klasične genetike gotovo nemoguće. CRISPR omogućuje kiruršku preciznost, osiguravajući brze i kontrolirane rezultate.
Međutim, postoji očita prepreka: društvena percepcija. Izraz „genetski modificiran” i dalje budi otpor dijela javnosti, iako mnoga regulatorna tijela već priznaju da se uređivanje gena koje ne uvodi vanjsku DNK procjenjuje drugačije od konvencionalnih transgenih organizama.
Na primjer, 2016. godine Sjedinjene Američke Države su dozvolile stavljanje na tržište gljive modificirane pomoću CRISPR-a bez dodatnog procesa verifikacije, jer nije sadržavala strani DNK. Taj presedan može olakšati put gljivama namijenjenim proizvodnji mikroproteina, posebno ako ispunjavaju stroge norme sigurnosti hrane.
Potencijal za budućnost
Razvoj gljiva optimiziranih pomoću CRISPR-a predstavlja realističan put ka povećanju ponude proteina s manjim ekološkim otiskom. To samo po sebi neće riješiti klimatsku krizu, ali može doprinijeti stvaranju raznovrsnijeg, otpornijeg i dostupnijeg prehrambenog sustava.
Poboljšanje učinkovitosti smanjuje troškove i olakšava dostupnost proizvoda većem broju ljudi, a istraživanja novih okusa i tekstura mogu ukloniti kulturološke barijere. Paralelno s tim, javne politike — od održivije institucionalne nabave do poticaja za inovacije u prehrani — mogu ubrzati ovu transformaciju.
Budućnost u kojoj će dio proteina na svijetu dolaziti iz genetski modificiranih gljiva nije znanstvena fantastika. To je sljedeći, diskretan, ali moćan alat koji služi smanjenju utjecaja naše prehrane na okoliš bez odricanja od užitka u jelu.
